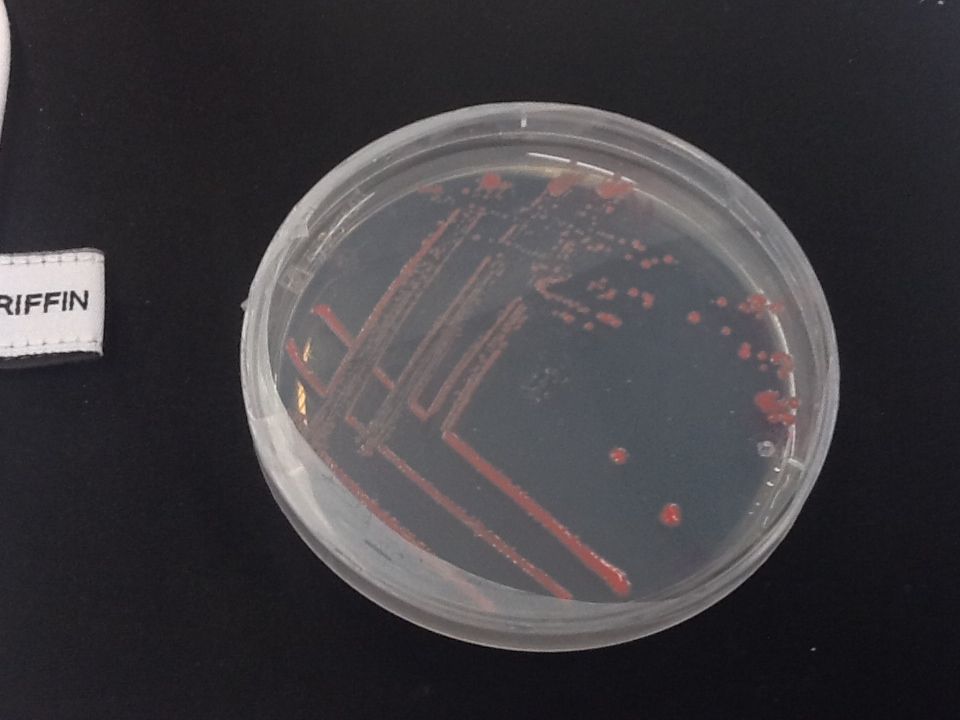
Microbiology Bacterial Plate Bacteria on Agar plate

Impressionen und Methoden

Forschungsausfahrten
Forschungsschiffe ermöglichen uns den Zugang zu Wasserproben aus den Meeren und der Tiefsee. Molekular-ökologische Fragestellen können mit Umweltproben beantwortet werden. Wo findet bakterieller Zuckerabbau unter welchen Bedingungen statt?

Automatische Fluoreszenz-Mikroskopie
Fluoreszenz-Mikroskopie mit automatischer Bildaufnahme hilf uns dabei den Abbau und die Aufnahme von Zucker durch Bakterien zu beobachten. Die Mikroorganismen werden softwarebasiert auf hunderten von Bildern gezählt und ausgewertet.
Auf Social Media
Wissenschaftskommunikationskanal von Nahja Busse:
Science Slam von Laura Pareigis:

Molekulare Ökologie
Molekulare Ökologie ist die Untersuchung der Wechselwirkungen zwischen Organismen untereinander und mit ihrer Umwelt unter Verwendung von Werkzeugen aus der Genetik und Molekularbiologie, um Beziehungen, Vielfalt und Evolution zu verstehen. Wir konzentrieren unsere Forschung auf das marine Mikrobiom und die Wechselwirkungen zwischen marinen Bakterien untereinander und mit ihrer Umwelt.

Steriles Arbeiten
Lebende Bakterien- und Algenkulturen dürfen nicht mit anderen Mikroorganismen aus der Luft verunreinigt werden. Daher finden diese Arbeiten stets unter der sterilen Werkbank statt.

Kultivierung von marinen Bakterien
Marine Bakterien haben andere Anforderungen als terrestrische Bakterien. Viele marine Mikroben wachsen unter Standardlaborbedingungen nur langsam oder gar nicht. Wir kultivieren Reinkulturen mariner Bakterien mit verschiedenen Medien auf Basis synthetischer Meerwasser-Zusammensetzungen. Durch Anpassung der Kohlenstoff-Konzentration simulieren wir natürliche, nährstoffarme marine Umgebungen. Dies ermöglicht uns, das bakterielle Verhalten unter verschiedenen Bedingungen zu untersuchen.

Mikroskopie
Mit Hilfe eines Fluoreszenzmikroskops kann man die Aufnahme von fluoreszenzmarkierten Polysacchariden durch Bakterien auf Einzelzell-Ebene sichtbar machen.

Sequenzierung
Um die DNA einer bakteriellen Zelle oder eines Mikrobioms zu untersuchen, müssen wir die DNA sequenzieren. Dies bedeutet, dass wir die genaue Reihenfolge der Bausteine (A, T, C und G) in einem DNA-Strang bestimmen. Wir verwenden dazu ein Nanopore-Minion-Sequenziergerät, das es uns ermöglicht, die DNA-Struktur mit hoher Genauigkeit zu analysieren. Durch die Sequenzierung können wir Einblicke in die genetische Zusammensetzung und die Funktionen der Mikroorganismen gewinnen.
Mikrobiologie
Die von uns untersuchten Meeresmikroben werden in unserem Labor kultiviert. So können wir ihr Wachstum unter verschiedenen Bedingungen (z. B. Temperatur, Kohlenstoffquelle, pH) testen und herausfinden, wie weitreichend ihre Fähigkeiten sind und ob diese ihrem genetischen Potenzial entsprechen.

3D Drucker
Die MiCarb-Gruppe nutzt den 3D-Druck zur Herstellung von alltäglichen Laborgeräten, darunter Objektträgerboxen, Vortexer, Röhrchenaufbewahrungsboxen, Gestelle in verschiedenen Größen, Klammern und Clips sowie einige einzigartige Designs, die speziell für unsere Anwendungen entwickelt wurden. Der 3D-Druck senkt die Kosten, minimiert den Versandaufwand und ermöglicht es uns, projektbezogene Lösungen direkt im Labor zu entwickeln.

PCR und DNA
Um rauszufinden um welche Art es sich handelt, bedienen wir uns einer molekularen Technik: Die 16S rRNA Sequenzierung. Klingt kompliziert, ist es auch, deswegen hier in kurz: Die 16S rRNA ist wie ein Fingerabdruck einer Art. Wenn wir es also analysieren und mit anderen “Fingerabrücken” vergleichen, können wir sagen ob sie den gleichen oder einen anderen Abdruck haben und so identifizieren wir die Arten.
Hochdruck-Flüssigkeits-Chromatographie (HPLC)
Wir nutzen die HPLC in Form einer Größenausschlusschromatographie (Sephadex G-50&G-75/G-25), um Moleküle im Kulturüberstand nach ihrer Größe zu trennen. So können wir untersuchen, ob Bakterien komplexe Zucker direkt aufnehmen (selfish uptake) oder ob sie diese, durch freigesetzte Enzyme im Medium, in kleinere Fragmente abbauen. Durch den Vergleich mit molekularen Standards, lassen sich dabei spezifische Abbauprodukte identifizieren und Rückschlüsse auf die Art des Zuckerabbaus ziehen.

Filtern, filtern, filtern
Die Trennung von Materie und Wasser passiert durch Filtration. Somit fangen wir auch die Mikroorganismen aus dem Wasser auf Filtern.
Fluoreszenz assisstierte Zell Sortierung (FACS)
Fluoreszenz-markierte Bakterien können sortiert und unabhängig untersucht werden. Dadurch lassen sich bakterielle je nach Eigenschaft und Färbung von einander trennen.



















